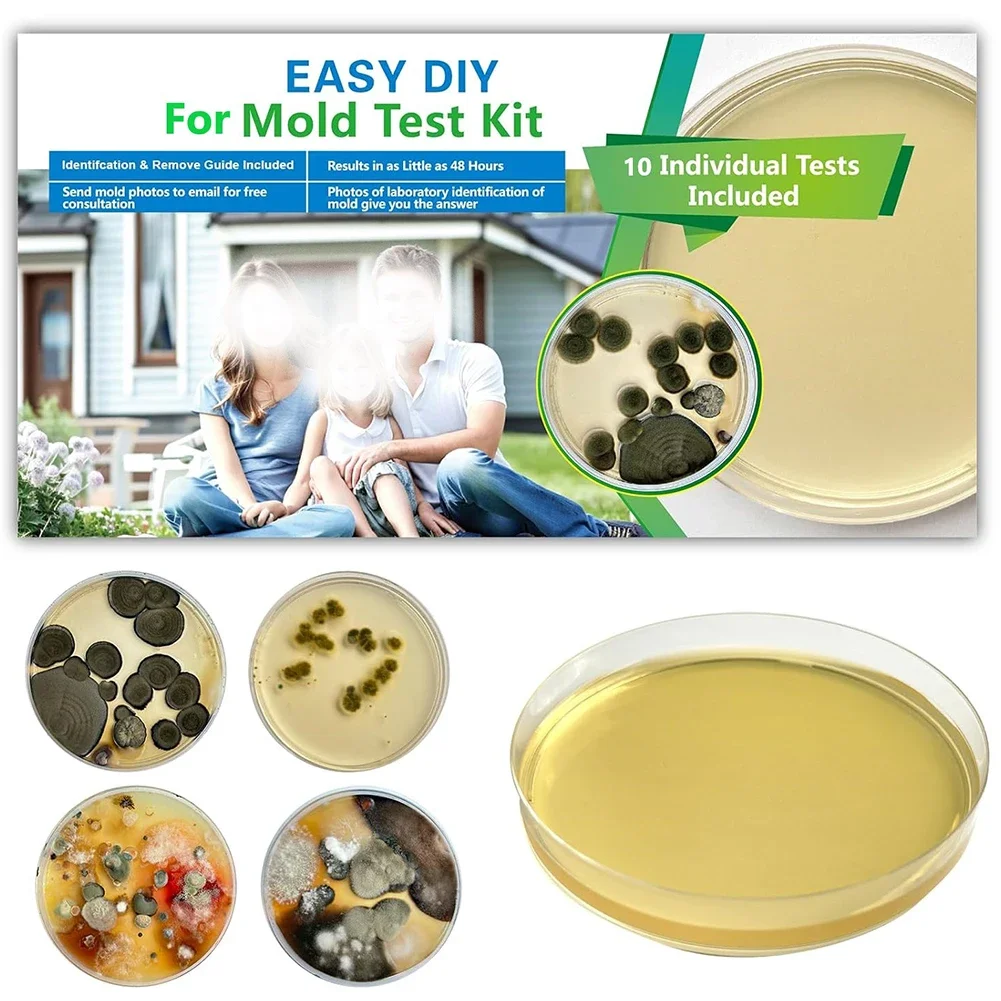
thumb

For Mold Testing Kit Home DIY For Mold Testing HVAC System Kit Detector For MOLD Testing Kit Test Measurement Inspection
Customers also viewed

$33.10
Новинка, оригинал, для ноутбука Dell Inspiron 15 7000 7591, задняя крышка ЖК-дисплея, передняя рамка, верхняя Подставка для рук, Нижняя основа, Фотоэлементы с клавиатурой, петли
aliexpress.ru
$81.28
LISM Sweetheart Elegant Vestido De Novia Boho Lace Up Back Formal Wedding Dress Chiffon Luxury Floor Length Bride Gown Fancy
aliexpress.ru
$3.88
Hairpin Ladies Large Clip Female Hair Alloy Women Metal Decor Lady Gold Alligator Clips
aliexpress.ru
$3.73
10 Pcs Girl Hair Band Women 3mm Headband Ties for Women's Headbands Girls Manual Headgear Clasp
aliexpress.ru
$1.46
Колпачок пылезащитные Чехлы аксессуары шарнирный Декор гетры запасные части резиновые универсальные практичные экономит усилия
aliexpress.ru
$12.98
For Toyota FJ Cruiser Folding Key Shell Folding Key Case Interior Accessories Key Case For Car FJ Cruiser Key Chain Key Ring
aliexpress.com
$70.00
2021 HIFU Machine Ultrasound Face 10000 Shots Exchangeable Facial Body Cartridge Applicable machine version 2.0.H/2.0.M/2.3.F
aliexpress.com
$77.00
Short-sleeved men's t-shirt lovers with loose ONE point sleeves 2019 summer new Y9AK190
aliexpress.com
$15.55
1:43 Diecast Vehicles 10cm BMW M4 BMW M6 Aolly Sports Car Pull Back Car Ornaments Car Model Children Kids Toys
aliexpress.com
$30.46
Men's T-shirt Shorts Set Oversized Retro Classic Pattern Summer Casual Swimming Comfortable Swimsuit Fashion 3D Printed Harajuku
aliexpress.com
$23.44
Для BMW S1000RR M1000RR R1250GS R 1250 GS 1290 аксессуары для супер приключений винт для датчика давления в шинах мотоцикла
aliexpress.ru
$7.80
Beibehang модная декоративная роспись настенная бумага морской пейзаж кокосовая пальма пейзажная живопись гостиная фон 3d обои
aliexpress.ru
$6.15
1 шт. бамбуковая круглая вязальная спица, полированная, легкая, для рукоделия: свитеров, шапок, шарфов, перчаток, принадлежности для ручного вязания
aliexpress.ru
$9.74
НОВАЯ аниме-фигурка Disney Zootopia 2, Джуди Ник, карнавальный день, флокированная кукла, модель, слепая коробка, игрушки, настольные украшения, рождественские подарки
aliexpress.ru
$0.76
Безопасный, быстрый, стабильный ток, черный кабель для зарядки умных часов, USB-адаптер для умных часов, зарядное устройство для умных часов, кабель для умных часов
aliexpress.ru
$14.00
Новинка: Модный женский шифоновый топ свободного кроя с цветочным принтом, весна-лето, с круглым вырезом, длина 7/8
aliexpress.ru
$31.73
Водонепроницаемая походная куртка свободного кроя с капюшоном, множеством карманов, молодежная, модная, из полиэфирного волокна, с длинными рукавами, на молнии
aliexpress.ru
$26.81
Лыжные брюки Thiened Fce на подкладке, мужские зимние ультраморозостойкие теплые мягкие брюки для спецодежды, повседневные прямые брюки...
aliexpress.ru
$17.51
1X A2X0R71011 A2XKR71033 нижний прижимной ролик фьюзера для Konica Minolta C558 C658 C554 C654 C754
aliexpress.ru
$29.00
Корейский Sle Ele, уникальный плиссированный жилет irt, женский летний дизайн, модный возрастной плиссированный топ без рукавов, повседневный свободный крой
aliexpress.ru
$5.35
Весенние белые кроссовки номер 39, оригинальные мужские кроссовки для тенниса D, спортивная обувь класса люкс, широкая новогодняя обувь
aliexpress.ru
$4.16
Сумка-светильник для кошелька, перезаряжаемая светодиодная лампа, брелок в форме сердца, кошелек-фонарик для женщин, для мамы, женский рюкзак, сумка на плечо
aliexpress.ru
$32.17
Для CB1000 Hornet SP 2025 рычаг переключения передач, датчик защиты CB1000 Hornet 2025- защита панелей заполнения рамы мотоцикла
aliexpress.ru
$36.62
Дефектная литая под давлением SUN STAR масштаб 1:43 Renault 4L PARISIENNE 1964, модель автомобиля из сплава, Коллекционная игрушка, подарок, сувенир, украшение для дисплея
aliexpress.ru
$25.56
ABUL-Идеально подходит для керамики, для глины и художественных проектов — набор деревянных керамических инструментов из 3 предметов для лепки и моделирования
aliexpress.ru
$23.99
Коврики в багажник на заказ для Honda M-NV 2020-2027, кожаный грузовой вкладыш, аксессуары для автомобиля
aliexpress.ru
$2,578.38
Электрический городской велосипед с двигателем 750 Вт, 7 скоростями, рамой из сплава, дисковыми тормозами, 26 дюймов, для города и бездорожья
aliexpress.ru
$45.00
1108100-MK01-BH01 Электронная педаль акселератора в сборе Датчик педали акселератора для Changan
aliexpress.ru
$16.95
Светящаяся в темноте цепь из прочного ПВХ-пластика, многоразовая, для Хэллоуина, вечеринок, декора дома с привидениями, реквизит
aliexpress.ru
$280.60
Игровая мышь G Wolves HSK PRO 4K с датчиком PAW3950, 140IPS, проводная, 20000DPI, легкая, для VALORANT, аксессуар для ПК
aliexpress.ru
$9.53
Girls Circus Ringmaster Magician Costume Long Sleeve Tassel Epaule Tutu Leotard Dress for Xmas Halloween Lion Tamer Cosplay Set
aliexpress.ru
$14.21
Bobisty 3 Pairs Silver Needle Stud Hoop Earrings Set for Women Dainty Small Stud Hoop Stacks Earrings for Multiple Piercings
aliexpress.ru
$28.56
Запчасти для креплений сноуборда: универсальные быстросъемные крепления, запасные части для ремонта, аксессуары для сноубордического снаряжения
aliexpress.ru
$47.71
Корейская женская утепленная куртка из искусственного меха под овчину, осенне-зимняя новинка, универсальная теплая короткая куртка на молнии с хлопковой подкладкой
aliexpress.ru
$63.26
В наличии Loungefly Disney Mickey Vespa Epcot Festival Фестиваль еды и вина Мини-рюкзак Детские праздничные подарки
aliexpress.ru
$112.46
Firstfloor из смешанного волокна в стиле ретро Fair Isle Long Sve открытый кардиган женский вязаный свитер для поездок на работу Sle стандартного кроя
aliexpress.ru
$141.69
Женская футболка Bodhl в полоску с вырезами, универсальная, для ношения под одеждой, из хлопка и вискозы, свободного кроя, летняя, повседневная
aliexpress.ru
$62.07
Мужской костюмный пиджак с металлической цепочкой, повседневный, с длинными рукавами, свободного кроя, однотонный, осенний, модный, трендовый
aliexpress.ru
$282.25
Набор для заваривания чая Brew Deluxe, 21 предмет, 150 мл, 1 л, чайные чашки, блюдца, сахарница, позолоченный костяной фарфор, роскошный опыт заваривания (Haze B)
aliexpress.ru
$47.06
CH брендовая сумка через плечо с классическим узором и буквенным дизайном, которую можно носить через плечо, высокое качество, элегантная и модная новая женская сумка
aliexpress.ru
$46.77
Портативная машина для резки горячей проволоки для пенопласта, настольная нагревательная проволока, губка, жемчуг, хлопок, доска KT, пенопласт, резак XPS, 72 Вт
aliexpress.ru
$33.86
APMT1135PDER-PM4 APMT1604PDER-PM6 Фрезы для кукурузы Нержавеющая сталь Грубые фрезерные лезвия для стальных деталей Тип зубчатой канавки
aliexpress.ru